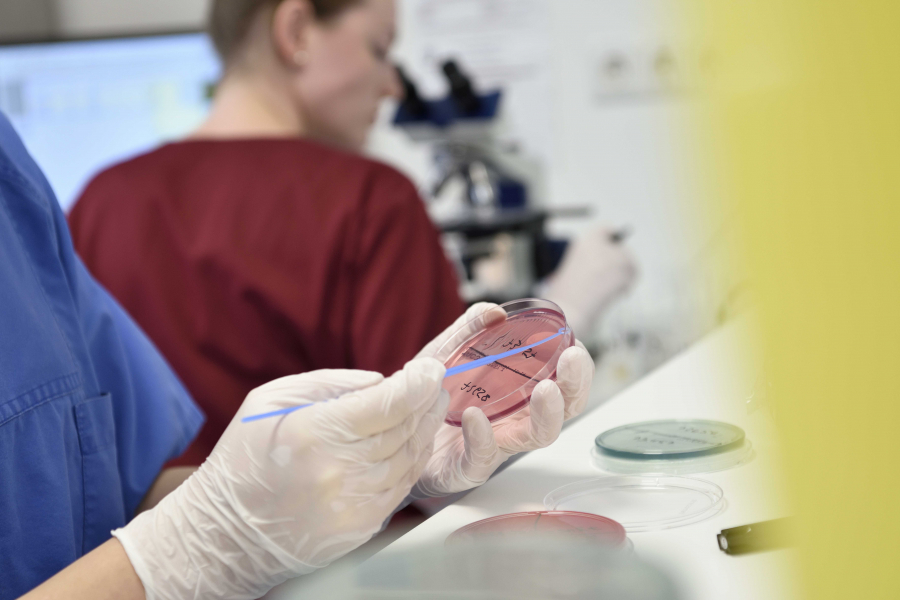
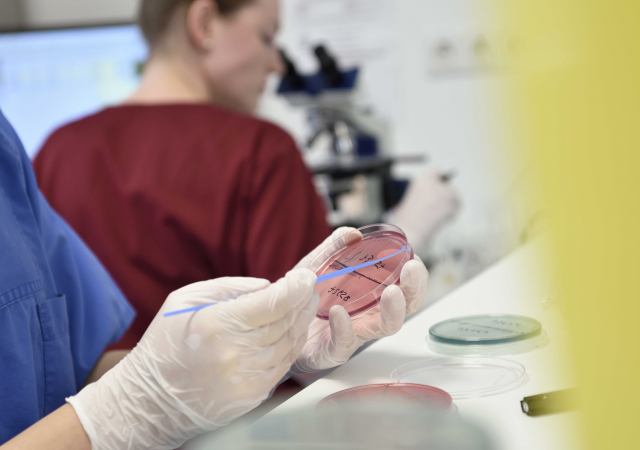
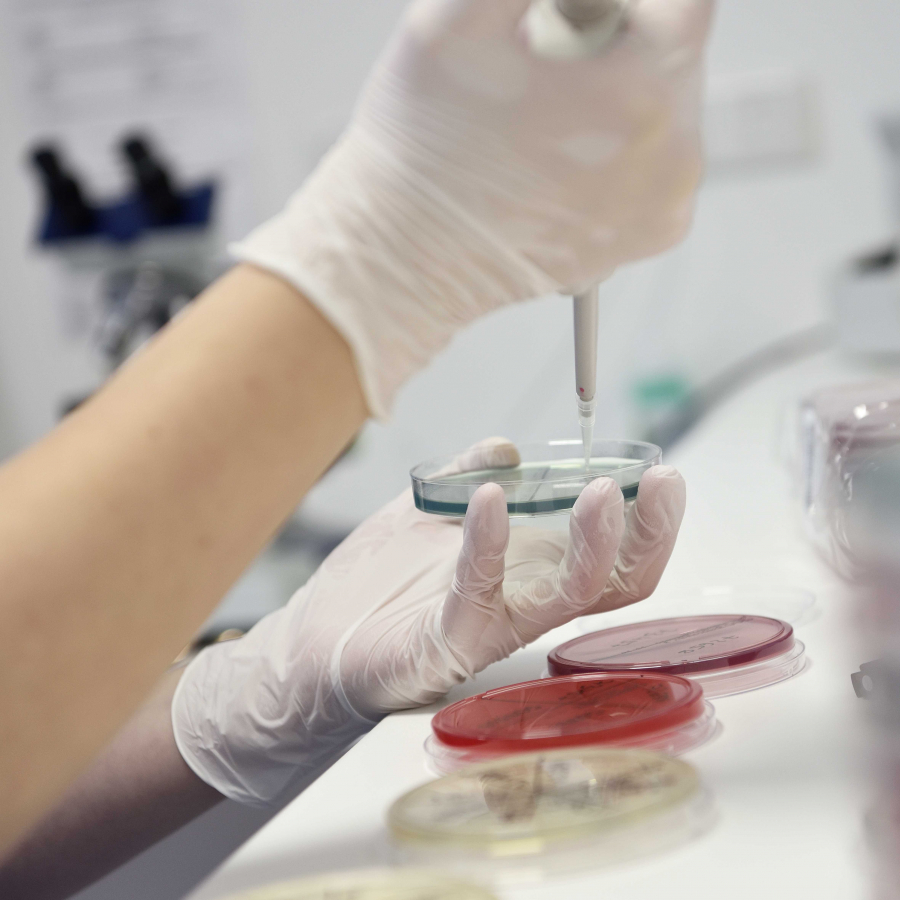
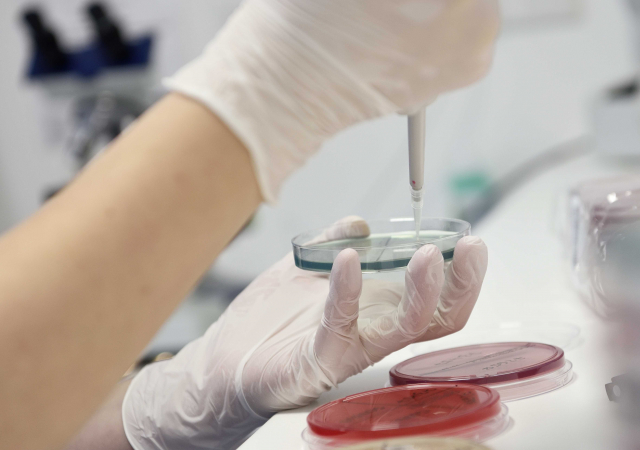

Standort Walsrode
Der Standort in Walsrode liegt im neu erbauten Ärztehaus in der Saarstr. 16. Die Praxis befindet sich im 1. OG. Die Leitung erfolgt durch Dr. S. Hanslik und Herrn Stermann. Das restliche Ärzteteam mit C. Chiarello, Dr. M. Kühme, D. Kuzenko und J. Fiebich sind hier ebenfalls in den Sprechstunden zu finden. Des Weiteren ist hier unser ambulantes OP Zentrum anzutreffen, wo Operationen in Narkose und Lokalanästhesie durchgeführt werden. Ebenso werden an diesem Standort die i.v. Chemotherapien durchgeführt.